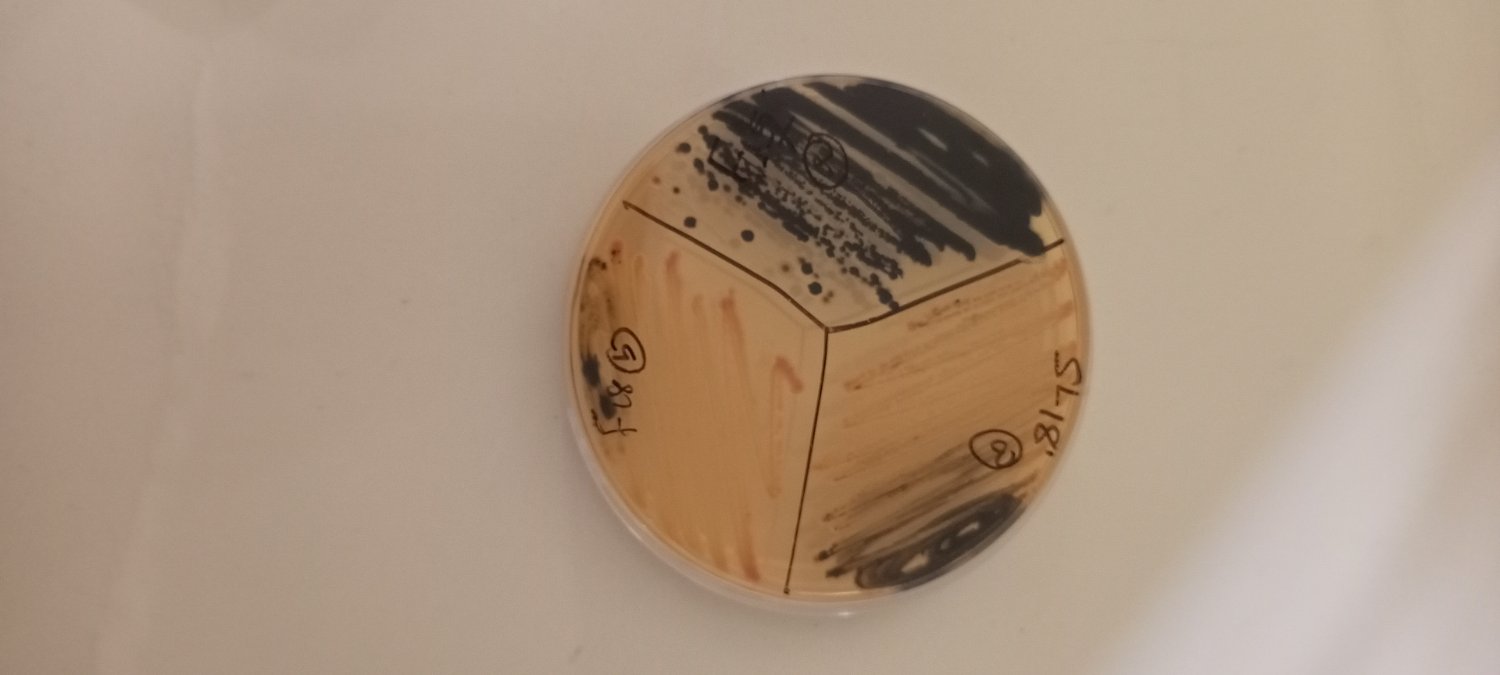
notinterested banner

@VivianIfeomaOj It is time for igbos to match the game and put together all credible evidence to push the wrong doing of then led Nigeria state. All these narratives are happening because our fathers and leaders did not act then because of so called one Nigeria
English